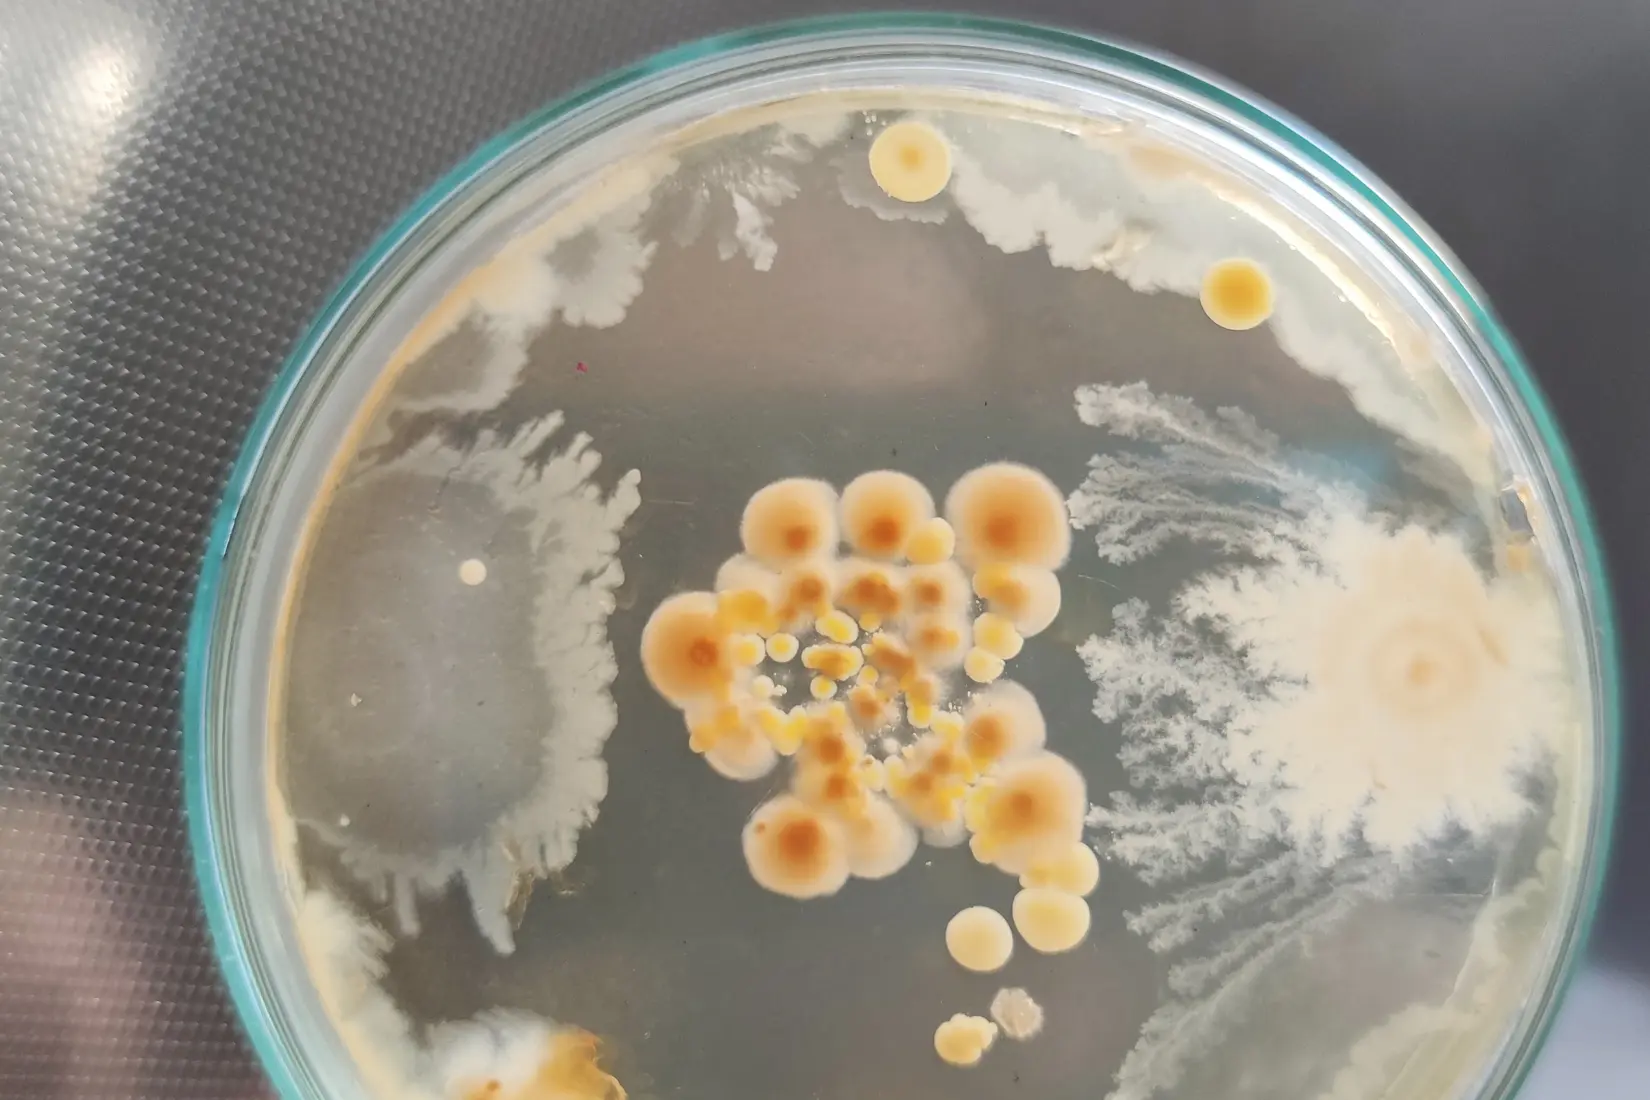
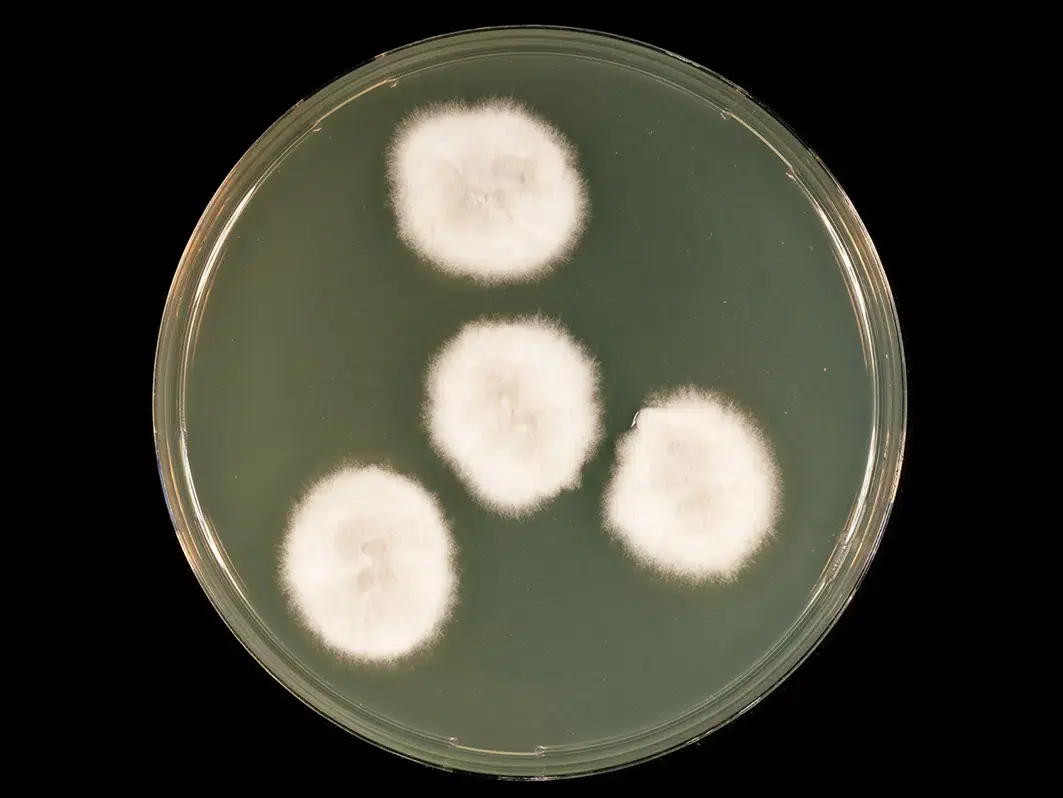

Taxonomie et Classification du Genre Scedosporium
Le genre Scedosporium appartient au Règne Fungi, Phylum Ascomycota, Classe Sordariomycetes, Ordre Microascales, Famille Microascaceae.
Ce genre comprend plusieurs espèces présentant des caractéristiques morphologiques et physiologiques proches, souvent regroupées sous le complexe Scedosporium apiospermum.
|
|
Règne | Champignons |
Phylum | Ascomycètes |
Classe | Sordariomycètes |
Ordre | Microéchelles |
Famille | Microascacées |
Genre | Scedosporium |
Téléomorphe | Pseudallescheria |
Méthodes d’Identification et Diagnostic de Laboratoire
L’identification précise du genre Scedosporium repose sur une combinaison de techniques phénotypiques et moléculaires :
01
Observation microscopique
- Examen direct au microscope optique ou à contraste de phase après coloration lactophénol-coton bleu.
- Recherche de hyphes septés, conidiophores isolés et conidies lisses non pigmentées.

02
Culture et isolement
- Isolement sur milieux sélectifs pour champignons filamenteux.
- Incubation à température ambiante (25–30°C).
- Observation des caractéristiques macroscopiques et microscopiques pour la différenciation d’espèces.

03
Identification moléculaire
Séquençage des gènes ITS (Internal Transcribed Spacer), β-tubuline ou calmoduline pour une identification spécifique.
Utilisation de PCR spécifique pour la détection rapide dans des échantillons environnementaux ou cliniques.

Surveillance Environnementale
La surveillance environnementale consiste à détecter la présence de spores de Scedosporium dans l’air, le sol ou l’eau à l’aide de techniques de prélèvement normalisées :
Échantillonnage de l'air :
utilisation d’impactors ou de filtres pour capturer les spores aériennes sur des milieux gélosés.
Échantillonnage du sol :
dilution en série et ensemencement sur milieux sélectifs pour champignons (SDA, MEA).
Surveillance de l'eau :
iltration sur membranes suivie d’une culture sur milieux nutritifs adaptés.
Isolement et Culture en Laboratoire
L’isolement du genre Scedosporium repose sur des procédures aseptiques :
01
Prélever l’échantillon (sol, eau, air ou surface).

02
Ensemencer sur un milieu nutritif adapté (Sabouraud, Czapek-Dox).
03
Incuber à 25–30 °C pendant 5 à 10 jours.

05
Examiner les structures microscopiques à l’aide de colorations fongiques (bleu coton lactophénolé).

Bonnes Pratiques de Sécurité et Prévention

Pour limiter les risques liés à la manipulation ou à la propagation :